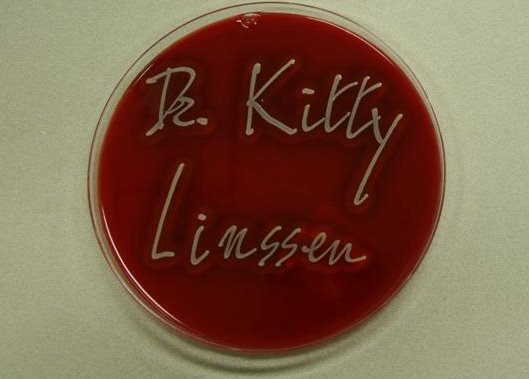

Op 22 november 2007 heeft dr. C.F.M. (Kitty) Linssen† (zie CV), microbioloog in het azM, haar proefschrift zeer succesvol verdedigd. De titel van het proefschrift is:‘Diagnostic value of bronchoalveolar lavage in infectious disorders’.
Voor het eerst in de geschiedenis van de Universiteit Maastricht werd een promotie begeleid door twee vrouwelijke hoogleraren als promotor — een bijzonder en betekenisvol moment, zoals ook door de pro-rector werd benadrukt.

Foto: kweekplaat
Diezelfde dag is er een minisymposium georganiseerd in Maastricht getiteld: ‘BAL masqué: the mystery of BAL’.Tijdens dit minisymposium is dieper ingegaan op de diagnostische waarde van BAL zowel op de intensive care, als bij infectieuze en niet infectieuze aandoeningen. Er waren ruim 50 belangstellenden.
Programma BAL Congres 22-11-2007
Uitreiking prof. dr. Jan A. Jacobs Award
Aan het eind van dit symposium is voor de tweede maal de prof. dr. Jan A. Jacobs BAL award uitgereikt aan Riet Schmitz en Yvonne Nijsen. Deze prijs is ter beschikking gesteld door de ild care foundation, de afdeling longziekten en medische microbiologie van het azM.
Jury Rapport
Naar het oordeel van de jury heeft Riet (M.P.J.) Schmitz, leidinggevend analiste van de subafdeling eiwitchemie van het laboratorium van de afdeling Klinische Chemie, een substantiële bijdrage geleverd aan de kwaliteit van het bewerken van BAL-vloeistof in het azM gedurende vele jaren. Zij valt op door haar enthousiasme voor het onderwerp, perfectionisme en uitermate zorgvuldige rapportage in het unieke ballenboek.
Volgens de jury heeft Yvonne (I.E.J.) Nijsen, analiste van de afdeling Medische Microbiologie, een substantiële bijdrage geleverd aan de kwaliteit van het bewerken van BAL-vloeistof in het azM.
Zij valt op door haar enthousiasme voor het onderwerp, goede ideeën, bereidheid om bij te leren en betrouwbaarheid.
De inzet van Riet en Yvonne is essentieel voor optimale patiëntenzorg en vormt de basis voor de kwaliteit van wetenschappelijk onderzoek.

Foto: links Riet Schmitz, rechts Yvonne Nijsen
BAL
Longinfecties vormen een groot probleem, vooral bij patiënten die op de intensive care worden verpleegd. In de diagnostiek van dergelijke longaandoeningen kan bronchoalveolaire lavage (BAL) ofwel longspoeling een waardevolle aanvulling betekenen op het traditionele traject van laboratoriumtesten, longfunctietesten en radiologisch onderzoek. Vooral het aantonen van zogenaamde intracellulaire bacteriën is hierbij van belang gebleken. De foto’s laten afbeeldingen van bacteriën zien in cellen te vinden in BAL-vloeistof van patiënten met een longinfectie.

Foto’s: Voorbeelden van intracellulaire bacteriën.